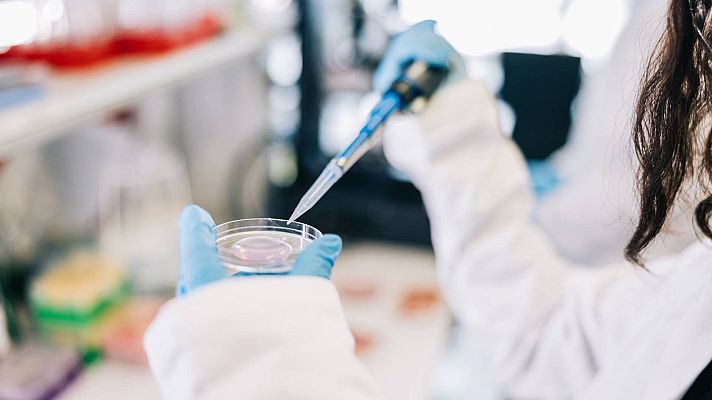
Informativo 24h - La larva migratoria cutánea, una infección más frecuente en perros y gatos que afecta a humanos

Informativo 24h
La larva migratoria cutánea, una infección más frecuente en perros y gatos que afecta a humanos
Javier Membrillo, portavoz de la Sociedad Española de Enfermedades Infecciosas y Microbiología Clínica, explica las particularidades de esta...
14/06/2023 00:04:14